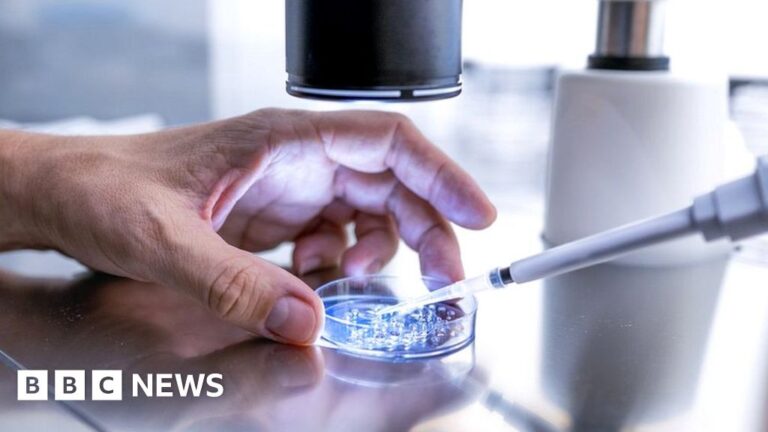

[ad_1]
చిత్ర మూలం, కార్లోస్ డ్వార్టే
యునైటెడ్ స్టేట్స్లో ఇన్విట్రో ఫెర్టిలైజేషన్ అనేది వంధ్యత్వ చికిత్స యొక్క సాధారణ రూపం.
స్తంభింపచేసిన పిండాలను పిల్లలుగా పరిగణిస్తారని మరియు అనుకోకుండా నాశనం చేయబడితే బాధ్యత వహించవచ్చని అలబామా సుప్రీం కోర్ట్ యొక్క తీర్పు పునరుత్పత్తి ఆరోగ్యంపై U.S.
ఈ నిర్ణయం తర్వాత, దక్షిణ US రాష్ట్రంలోని అతిపెద్ద ఆసుపత్రి క్రిమినల్ ప్రాసిక్యూషన్కు గురికావాలనే భయంతో ఇన్ విట్రో ఫెర్టిలైజేషన్ (IVF) సేవలను నిలిపివేసింది.
బర్మింగ్హామ్ హెల్త్ సిస్టమ్లోని అలబామా విశ్వవిద్యాలయం మహిళల అండాశయాల నుండి గుడ్ల సేకరణను కొనసాగిస్తామని ప్రకటించింది. అయితే ఇది IVF ప్రక్రియలో తదుపరి దశను నిలిపివేస్తుందని, ఇందులో గుడ్డును గర్భాశయంలో అమర్చడానికి ముందు స్పెర్మ్తో ఫలదీకరణం చేయడం జరుగుతుంది.
“IVF ద్వారా పిల్లలు పుట్టడానికి మా రోగుల ప్రయత్నాలపై ఇది ప్రభావం చూపుతుందని మేము చింతిస్తున్నాము” అని రాష్ట్ర ప్రముఖ ఆరోగ్య సంరక్షణ ప్రదాతలు ఒక ప్రకటనలో తెలిపారు.
“అయినప్పటికీ, IVF చికిత్స కోసం సంరక్షణ ప్రమాణాన్ని అనుసరించినందుకు రోగులు మరియు వైద్యులు క్రిమినల్ ప్రాసిక్యూషన్ లేదా శిక్షాత్మక నష్టాలను ఎదుర్కొనే సామర్థ్యాన్ని మేము తప్పనిసరిగా అంచనా వేయాలి.”
అలబామా మరియు ఇతర ప్రాంతాలలో సంతానోత్పత్తి చికిత్సలపై తీర్పు ప్రతికూల ప్రభావాన్ని చూపుతుందని వైద్య నిపుణులు మరియు పునరుత్పత్తి న్యాయవాద సమూహాలు హెచ్చరించాయి.
కన్జర్వేటివ్ గ్రూపులు ఈ తీర్పును స్వాగతించాయి, చిన్న పిండం కూడా చట్టపరమైన రక్షణకు అర్హమైనది అని వాదించారు.
ఈ కేసు ఎందుకు తలెత్తింది మరియు కోర్టు ఏమి నిర్ణయించింది?
సంతానోత్పత్తి క్లినిక్లలో తమ బిడ్డలను కోల్పోయిన ముగ్గురు జంటలు 2020లో దాఖలు చేసిన తప్పుడు మరణ వ్యాజ్యాల నుండి ఈ కేసు వచ్చింది.
రోగి పిండాలను నిల్వ చేసిన ప్రాంతంలోకి తిరుగుతూ, పిండాలను తాకి, ప్రమాదవశాత్తు వాటిని పడిపోయాడు. ఫలితంగా, పిండం నాశనమైంది.
ఈ జంట రాష్ట్రానికి చెందిన చిన్నపాటి మరణ చట్టం కింద రిప్రొడక్టివ్ హెల్త్ సెంటర్ మరియు మొబైల్ క్లినిక్ అసోసియేషన్పై దావా వేసేందుకు ప్రయత్నించారు. ఈ చట్టం పిండాలను కవర్ చేసినప్పటికీ, ఇది విట్రో ఫెర్టిలైజేషన్ ఫలితంగా ఏర్పడే పిండాలను ప్రత్యేకంగా కవర్ చేయలేదు.
పిండం వ్యక్తిగా లేదా బిడ్డగా అర్హత పొందనందున తప్పుడు మరణ వ్యాజ్యాన్ని కొనసాగించలేమని దిగువ కోర్టు తీర్పు చెప్పింది.
తప్పుడు మరణ చట్టం “పుట్టబోయే పిల్లలందరికీ, వారి నివాస స్థలంతో సంబంధం లేకుండా” వర్తిస్తుందని తీర్పు చెప్పింది.
ప్రధాన న్యాయమూర్తి టామ్ పార్కర్ మెజారిటీ అభిప్రాయంతో ఏకీభవిస్తూ, “మానవులందరూ పుట్టకముందే భగవంతుని ప్రతిరూపాన్ని కలిగి ఉంటారు మరియు దేవుని మహిమను తగ్గించకుండా వారి జీవితాలు నాశనం చేయబడవు” అని రాశారు.
అలబామా యొక్క వంధ్యత్వ రోగులకు సంబంధించిన చిక్కులు ఏమిటి?
ఈ తీర్పు IVFని నిషేధించలేదు లేదా పరిమితం చేయలేదు మరియు వాస్తవానికి, దావా వేసిన జంటలు IVF విధానాన్ని చురుకుగా కోరుతున్నారు.
కానీ ఈ నిర్ణయం అలబామా చట్టం ప్రకారం IVF యొక్క కొన్ని అంశాలు చట్టబద్ధంగా ఉన్నాయా లేదా అనే దానిపై గందరగోళానికి కారణం కావచ్చు, నిపుణులు అంటున్నారు. పిండాలను మానవులుగా పరిగణించినట్లయితే, వాటిని ఉపయోగించడానికి మరియు నిల్వ చేయడానికి క్లినిక్లు ఎలా అనుమతించబడతాయి అనే ప్రశ్నలు తలెత్తవచ్చు.
పునరుత్పత్తి హక్కుల కేంద్రంలో జాతీయ పాలసీ డైరెక్టర్ ఎలిజబెత్ స్మిత్ BBCకి ఒక ప్రకటనలో తెలిపారు: [IVF] పిండాలు ఉపయోగించబడతాయి, కానీ అవి కూడా ఉపయోగించబడవు.
“పుట్టబోయే పిల్లలకు చట్టపరమైన వ్యక్తిత్వాన్ని అందించే చట్టాన్ని రూపొందించడం వలన ఇన్ విట్రో ఫెర్టిలైజేషన్ యొక్క ఉపయోగం కోసం భయంకరమైన పరిణామాలు ఉండవచ్చు, ఇది చాలా మంది కుటుంబాలు నిర్మించడానికి ఆధారపడే శాస్త్రం.”
చట్టం చుట్టూ ఉన్న అస్పష్టత రోగులకు కూడా విస్తరించవచ్చు, ఈ ప్రక్రియ అందుబాటులో ఉంటుందా లేదా చట్టబద్ధంగా ఉంటుందా అనే దాని గురించి వారు ఆందోళన చెందుతారు.
ఒక ప్రకటనలో, అలబామా స్టేట్ మెడికల్ అసోసియేషన్ ఇలా చెప్పింది, “ఈ నిర్ణయం యొక్క ప్రాముఖ్యత అలబామా మొత్తాన్ని ప్రభావితం చేస్తుంది, సంతానోత్పత్తిని కోరుకునే వ్యక్తుల కోసం ఎంపికలను పరిమితం చేస్తుంది, తద్వారా వారు తమ పిల్లలు, మనవరాళ్ళు, మేనకోడళ్ళు, మేనల్లుళ్ళు, కజిన్స్ మరియు ఇతరులకు బేబీ.” “సంఖ్య తగ్గే అవకాశం ఉంది.” ఒక కుటుంబం కలిగి. ”
యునైటెడ్ స్టేట్స్లో అబార్షన్ చర్చలో ఇది ఎలా ముడిపడి ఉంది?
U.S. సుప్రీం కోర్ట్ 2022లో దేశవ్యాప్తంగా అబార్షన్ హక్కులను కొట్టివేసినప్పుడు, ఈ సమస్యపై రాష్ట్రాలు తమ స్వంత చట్టాలను రూపొందించుకోవడానికి తలుపులు తెరిచింది.
ఆ నిర్ణయం నుండి, డెమొక్రాటిక్-నియంత్రిత రాష్ట్రాలు యాక్సెస్ను విస్తరించాయి, అయితే రిపబ్లికన్-నియంత్రిత రాష్ట్రాలు యాక్సెస్ని పరిమితం చేశాయి.
అలబామాలో గర్భం యొక్క అన్ని దశలలో అబార్షన్పై ఇప్పటికే పూర్తి నిషేధం ఉంది.
అలబామా నిర్ణయం “రోయ్ వర్సెస్ వేడ్ను సుప్రీం కోర్టు రద్దు చేసినప్పుడు మేము ఊహించినట్లుగానే ఉంది, కుటుంబాలు తీసుకునే కొన్ని వ్యక్తిగత నిర్ణయాలను రాజకీయ నాయకులు నిర్దేశించడానికి మార్గం సుగమం చేసారు” అని వైట్ హౌస్ పేర్కొంది. “ఇది ఒక రకమైన గందరగోళం జరుగుతోంది.”
అబార్షన్ వ్యతిరేకులు కూడా ఈ తీర్పును నిశితంగా గమనిస్తున్నారు. పిండం లేదా పిండం చట్టబద్ధంగా ఒక వ్యక్తిగా పరిగణించబడే ప్రశ్న అనేక రాష్ట్రాల్లో అబార్షన్ పరిమితులలో ఒక అంశం.
అలయన్స్ డిఫెండింగ్ లిబర్టీ అనే సంప్రదాయవాద క్రిస్టియన్ లా గ్రూప్ అలబామా పాలనను “జీవితానికి అద్భుతమైన విజయం”గా పేర్కొంది.
“ప్రతి మనిషి జీవితం గర్భం దాల్చిన క్షణం నుండి, పరిస్థితులతో సంబంధం లేకుండా విలువైనది” అని ప్రతినిధి డెన్నిస్ బర్క్ BBCకి ఒక ప్రకటనలో తెలిపారు. “అలబామా చట్టం ఈ ప్రాథమిక సత్యాన్ని గుర్తిస్తుందని కోర్టు సరిగ్గా పేర్కొన్నందుకు మేము కృతజ్ఞులం.”
ఇతర అబార్షన్ వ్యతిరేక కార్యకర్తలు తమ దృష్టిలో, IVF అనేది అబార్షన్ కంటే తక్కువ స్పష్టమైన నైతిక సమస్య అని చెప్పారు.
2018లో అబార్షన్పై అలబామా రాజ్యాంగ భాషను రూపొందించడంలో సహాయం చేసిన న్యాయవాది ఎరిక్ జాన్స్టన్ BBCతో ఇలా అన్నారు: “ఫలదీకరణం చేసిన గుడ్డుకు రక్షణ అవసరమని ప్రో-లైఫ్ సంఘం సాధారణంగా చెబుతుంది.”
అయితే అబార్షన్ను వ్యతిరేకించే దంపతులు ఉన్నారని, పిల్లలను కనేందుకు ఇన్విట్రో ఫెర్టిలైజేషన్ను ఉపయోగించుకున్నారని ఆయన అంగీకరించారని, వారిని తాను ఎప్పుడూ విమర్శించబోనని అన్నారు.
“ఇది ఒక సందిగ్ధం, మరియు సందిగ్ధత సంతృప్తికరమైన సమాధానం కనుగొనలేదు,” అన్నారాయన.
మిగతా రాష్ట్రాల్లో ఏం జరుగుతుంది?
యునైటెడ్ స్టేట్స్లోని రాష్ట్రాలు ఒకదానికొకటి చట్టాలను కాపీ చేసుకుంటాయి మరియు యునైటెడ్ స్టేట్స్ ఈ పద్ధతిని అబార్షన్కి వర్తింపజేస్తుంది. కాంగ్రెస్ను ఆమోదించిన లేదా చట్టపరమైన సవాళ్లను ఎదుర్కొన్న చట్టాలు మరియు విధానాల గురించి రాష్ట్రాలు తరచుగా పరస్పరం సూచనలను తీసుకుంటాయి.
అలబామా తీర్పు రాష్ట్రంలో మాత్రమే వర్తిస్తుంది అయినప్పటికీ, స్తంభింపచేసిన పిండాలను చట్టబద్ధంగా పిల్లలు లేదా వ్యక్తులుగా పరిగణించాలనే భావనను ముందుకు తీసుకురావడానికి ఉద్దేశించిన శాసన ప్రయత్నమని నిపుణులు అంటున్నారు.ఇతర రాష్ట్రాల్లో వ్యాజ్యాలు తలెత్తవచ్చని ఆయన అన్నారు.
అయితే అలబామా నిర్ణయం రాష్ట్ర న్యాయస్థానంలో జారీ చేయబడినందున మరియు ఫెడరల్ లా కాకుండా రాష్ట్ర చట్టం యొక్క వివరణకు సంబంధించినది కాబట్టి, అబార్షన్ సమస్య వంటి ఈ ప్రత్యేక కేసు U.S. సుప్రీం కోర్టు ముందు ఉంటుందని వారు వాదించారు. కేసు పోటీ చేయబడుతుంది.
సెంటర్స్ ఫర్ డిసీజ్ కంట్రోల్ అండ్ ప్రివెన్షన్ ప్రకారం, 2021లో యునైటెడ్ స్టేట్స్లో IVF చికిత్స ఫలితంగా 97,128 మంది పిల్లలు జన్మించారు.
ఈ తీర్పు U.S. రాజకీయాలపై ఎలాంటి ప్రభావం చూపుతుంది?
U.S. సుప్రీం కోర్ట్ రో వర్సెస్ వేడ్ను రద్దు చేసినప్పటి నుండి డెమోక్రాట్లకు అబార్షన్ హక్కులు ఒక విజయవంతమైన సమస్యగా ఉన్నాయి, ఇది దాదాపు 23 నుండి 25 వారాల పిండం జీవితంలో అబార్షన్ చేసే రాజ్యాంగ హక్కుకు హామీ ఇచ్చింది.
అలబామా తీర్పు నేపథ్యంలో, డెమొక్రాటిక్ అభ్యర్థులు దేశవ్యాప్తంగా సంతానోత్పత్తి చికిత్సకు ప్రాప్యతను రక్షించే వేదికపై పోటీ చేయవచ్చు.
రిపబ్లికన్ రాజకీయ నాయకులు, మరోవైపు, యునైటెడ్ స్టేట్స్లో అబార్షన్ను నిషేధించాలని లేదా పరిమితం చేయాలని కోరుకునే మతపరమైన సంప్రదాయవాదుల పక్షాన ఉంటారు.
డోనాల్డ్ ట్రంప్కు వ్యతిరేకంగా పార్టీ నామినేషన్ రేసులో రిపబ్లికన్ అధ్యక్ష అభ్యర్థి నిక్కీ హేలీ గురువారం అలబామా సుప్రీంకోర్టు తీర్పును సమర్థించారు.
“నాకు, పిండం ఒక శిశువు,” ఆమె చెప్పింది. “మీరు పిండం గురించి మాట్లాడేటప్పుడు, మీరు నాతో జీవితం గురించి మాట్లాడుతున్నారు, కాబట్టి వారు దాని గురించి మాట్లాడినప్పుడు, అది ఎక్కడ నుండి వస్తుందో నాకు అర్థమైంది.”
మీరు వీటిపై కూడా ఆసక్తి కలిగి ఉండవచ్చు:
మనోన్ మరియు క్రిస్ వారి కుమార్తె ఎఫాకు జన్మనిచ్చినప్పటి నుండి గర్భం దాల్చలేకపోయారు.
[ad_2]
Source link